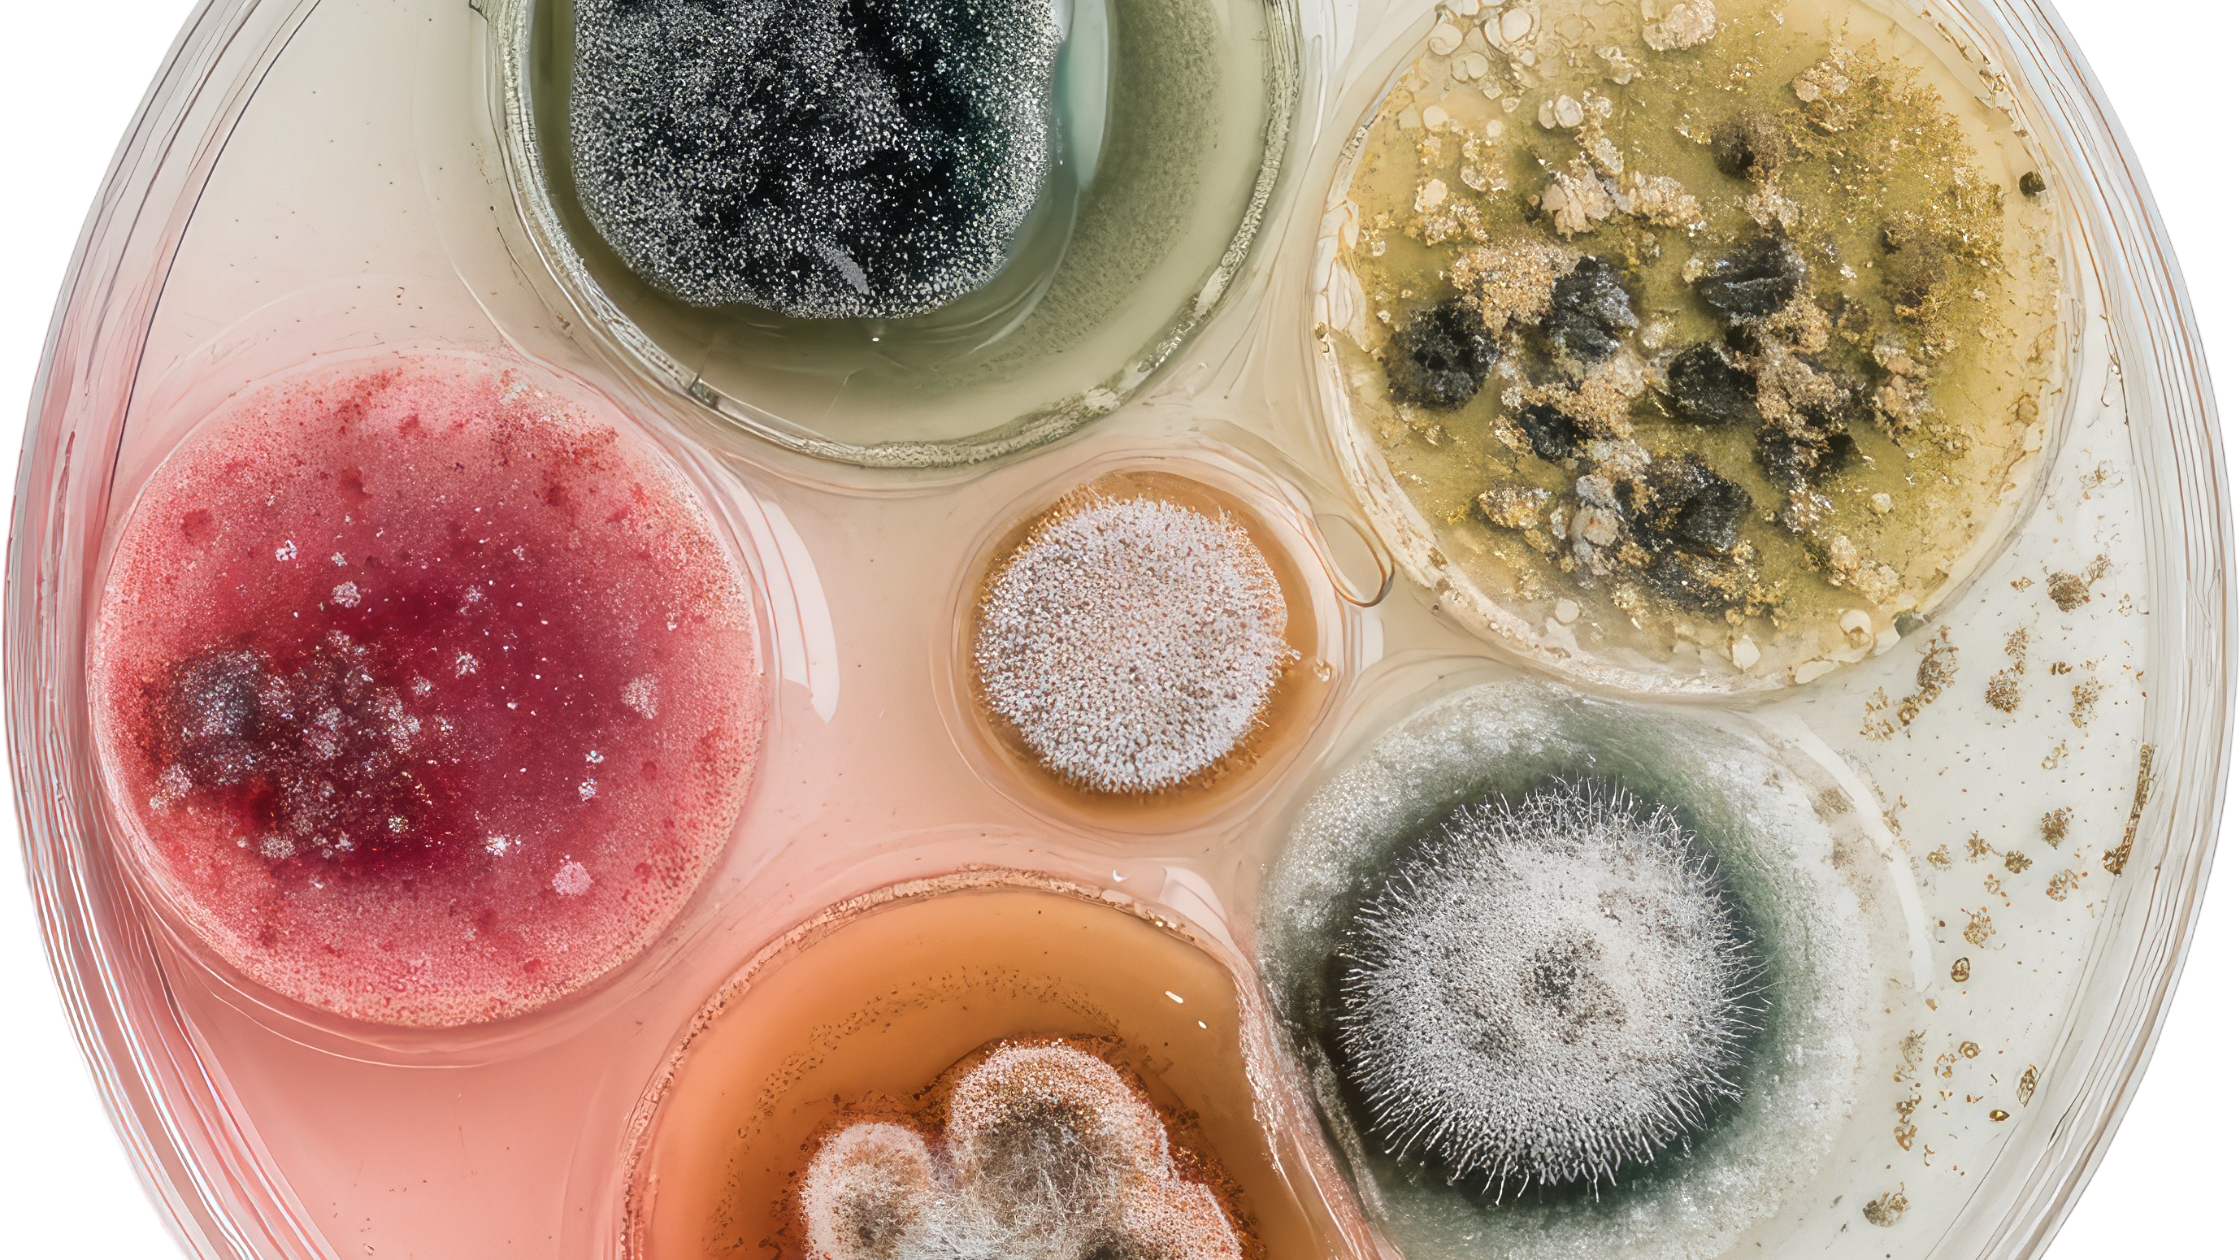
different types of mold growing on indoor surfaces

What Are the Different Types of Mold in a Home?
Mold in Homes: Not All Mold Is Created Equal
"Mold is everywhere." It sounds like the opening line of a horror movie, but it’s a scientific fact. While there are more than 100,000 known species of mold, many homeowners still ask, how many different types of mold are there that actually grow indoors?
The truth is, only a handful are commonly found growing in homes, and some of them can be downright dangerous.
At ZeroMold, we believe that understanding the different types of mold is a critical step toward safe, effective mold removal. Because not all mold is visible, and not all of it smells. But all of it has the potential to affect your health and your home.
Let’s break down the most common mold types in home environments, how to recognize them, and when to call in the pros for mold remediation.
Common Types of Household Mold
1. Stachybotrys chartarum (Black Mold)
Color: Slimy black or dark green
Where it grows: Cardboard, wood, drywall, and other cellulose-rich materials
Health risks: Produces mycotoxins; linked to respiratory issues, neurological symptoms, and immune suppression
Often referred to as “black mold,” this one gets all the headlines, and for good reason. It thrives in areas with chronic moisture problems. If you see this mold, don’t hesitate, professional mold remediation is essential.
2. Alternaria
Color: Dark green or brown with a velvety texture
Where it grows: Bathrooms, under sinks, around showers
Health risks: Asthma and allergy symptoms
Alternaria is one of the most common allergenic molds and spreads fast in damp indoor environments. Even minor water leaks can set the stage for its growth.
3. Aspergillus
Color: Varies. Often yellow-green, white, or black
Where it grows: Walls, insulation, HVAC systems
Health risks: Allergies, lung infections, and a condition known as aspergillosis
With hundreds of species under this umbrella, Aspergillus is a versatile and potentially harmful mold that should not be underestimated.
4. Penicillium
Color: Blue or green with a soft, velvety texture
Where it grows: Carpets, wallpaper, insulation, mattresses
Health risks: Respiratory issues and sinus inflammation
This fast-spreading mold is often a sign of water damage. If you see it, act quickly, mold removal may require replacing contaminated materials.
5. Cladosporium
Color: Olive green or brown
Where it grows: Wood, fabrics, HVAC vents
Health risks: Respiratory and skin irritation
Unlike many molds, Cladosporium can grow in both warm and cool areas. It’s hardy and can linger in carpets and upholstery, making it tough to fully remove without a thorough remediation plan.
6. Chaetomium
Color: White at first, then turns dark gray or black
Where it grows: Water-damaged drywall, baseboards, and ceilings
Health risks: Allergic reactions and potential neurological effects
Chaetomium has a cotton-like texture and is commonly found after long-term leaks. It shares many characteristics with black mold and is just as serious.
7. Acremonium
Color: Initially moist, turns powdery; colors vary from white, pink, gray, or orange
Where it grows: Condensation lines, drain pans, humidifiers
Health risks: Immune suppression and organ damage from prolonged exposure
Acremonium often coexists with Stachybotrys and Fusarium, which can make an already dangerous situation even worse.
8. Ulocladium
Color: Dark black
Where it grows: Kitchens, bathrooms, basements, and around windows
Health risks: Similar to black mold, can trigger allergies and asthma
Easily mistaken for Stachybotrys, Ulocladium requires moisture to thrive and is frequently found after flooding or leaks.
9. Fusarium
Color: Pink, white, or reddish
Where it grows: Damp carpets, wallpaper, and fabrics
Health risks: Can cause severe infections and damage to skin and nails
Fusarium grows quickly in water-damaged materials and can survive in colder environments.
10. Trichoderma
Color: White with green patches
Where it grows: Wet surfaces, particularly HVAC systems and filters
Health risks: Produces mycotoxins and can destroy building materials
This mold is dangerous both for health and for your home’s structure, it can contribute to rot and cause serious structural damage.
11. Mucor
Color: Thick, white or gray cotton-like patches
Where it grows: Near HVAC systems, damp carpet, or around leaky windows
Health risks: Can lead to mucormycosis, a rare but severe infection
This fast-growing mold should be taken seriously. If you spot it near vents, get professional help immediately.
12. Aureobasidium
Color: Pink, brown, or black that darkens with age
Where it grows: On wood, caulking, and behind wallpaper
Health risks: Can cause eye, skin, and nail infections
It may look like simple discoloration, but Aureobasidium spreads fast and should be professionally addressed.
When to Call the Pros for Mold Remediation
Here’s the truth: mold doesn’t go away on its own. If left untreated, it spreads fast and silently. If you see visible growth larger than 10 square feet, if it’s in your HVAC system, or if anyone in your home has allergies, asthma, or a compromised immune system, it’s time to call ZeroMold.
Our mold remediation process is non-toxic, eco-friendly, and designed to eliminate mold at the source without the destruction that traditional methods rely on. We use advanced fog technology that penetrates deep into materials and stops mold in its tracks, without harsh chemicals or unnecessary demolition.
Prevention Tips: Keep Mold Away for Good
Fix leaks immediately, plumbing, roofing, and HVAC.
Use dehumidifiers to maintain indoor humidity below 50%.
Run exhaust fans in bathrooms, kitchens, and laundry rooms.
Avoid carpet in damp areas like basements.
Clean and inspect regularly, especially under sinks and around windows.

The Bottom Line: Knowledge Is Power
Whether it’s black mold in the bathroom or Cladosporium in the basement, knowing the different types of mold you’re dealing with is half the battle. The other half? Calling ZeroMold to make sure it’s removed safely, effectively, and for good.
Need a mold inspection or help with mold removal? Reach out today and breathe easier tomorrow.
Frequently Asked Questions About Mold in Homes
1. How many different types of mold are there in a home?
There are thousands of mold species in the environment, but only a smaller number are commonly found indoors. When people ask how many different types of mold are there in a home, the answer is usually a handful of common ones like black mold, Aspergillus, and Penicillium.
2. What are the most common mold types in home environments?
Some of the most common mold types in home settings include black mold (Stachybotrys), Alternaria, Aspergillus, and Cladosporium. These molds tend to grow in damp areas like bathrooms, basements, and around leaks.
3. Are all different types of mold dangerous?
Not all different types of mold are equally harmful, but many can still affect your health. Some molds cause mild allergic reactions, while others, like black mold, can lead to more serious respiratory issues if left untreated.
4. How can I tell which type of mold is in my home?
It can be difficult to identify the exact mold type just by looking at it. Color, texture, and location can give clues, but professional testing is the most reliable way to confirm the different types of mold present in your home.
5. Do all mold types in home spaces need to be removed?
Yes, any mold types in home environments should be addressed as soon as possible. Even if the mold seems minor, it can spread quickly and lead to larger problems if not properly removed.




